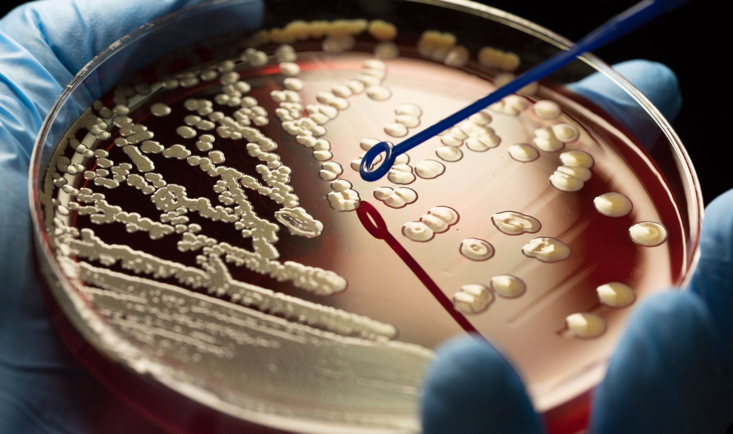

◆
◆
个人介绍
主讲教师:史晓晶
第3期
| 学校: | 忻州师范学院 |
| 开课院系: | 生物系 |
| 专业大类: | 生物科学类(0710) |
| 开课专业: | 生物科学 |
| 课程英文名称: | Microbiology |
| 学分: | 4.5 |
| 课时: | 48 |
课程介绍
微生物学是研究微生物及其生命活动规律的学科,内容包括微生物的形态结构、生长繁殖、生理代谢、生态分布、传染免疫、分类进化;微生物与其他生物的相互关系及其多样性;微生物的应用等。它既是生物学相关专业的一门专业基础课,又是处于生命科学前沿的极具潜力的独立学科,其相关知识与人类的生产和生活有着紧密的联系。通过本课程的学习,我们将获得对微生物世界的全面认识和科学思维的培养。
课程评价
课程章节
1

 视频
视频